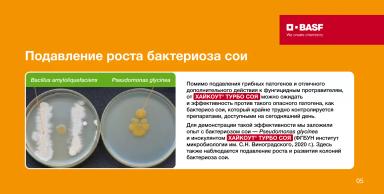
ХАЙКОУТ® ТУРБО СОЯ — турборежим питания и защиты сои

ХАЙКОУТ® ТУРБО СОЯ — турборежим питания и защиты сои
387
Для накопления белка соя потребляет много азота, причем большую часть — благодаря симбиозу с бактериями-ризобиями, которые вызывают образование фиксирующих атмосферный азот клубеньков на корнях и переводят его в усвояемую для культуры аммонийную форму. Такое обеспечение сои азотом является наиболее доступным агроприемом.
Чтобы добиться максимальной активности симбиотической азотфиксации, необходима инокуляция. Сегодня рынок предлагает широкий выбор инокулянтов для сои, но, чтобы сориентироваться в этом разнообразии и подобрать действительно эффективно работающий продукт, необходимо знать, на какие особенности подобных препаратов следует обращать внимание.
Компания BASF предлагает новую уникальную* систему обработки семян сои – новинку на российском рынке инокулянтов, которая не только обеспечивает полноценное азотное питание культуры, но и способствует подавлению комплекса грибных патогенов и бактериоза.
Подробнее о системе — в карточках, а также в фильме по
*Под словом «уникальный» подразумевается запатентованная формуляция инокулянта и питательного раствора ЭКСТЕНДЕР, содержащая штаммы ризобий 532С и Bacillus amyloliquefaciens штамм MBI600.
Опубликовано: 07 февраля, 2024 в 10:00
Похожие посты

Я с Вами, я на Direct Farm!

Оповещение об обработке посевов пестицидами пчеловодов

Что с озимней пшеницей?

Вредители кукурузы. Мониторинг за лётом чешуекрылых.
⚜️Яровой ячмень и Ризобакт⚜️


Нет комментариев